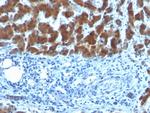
Retinol Binding Protein (RBP) Antibody in Immunohistochemistry (Paraffin) (IHC (P))

Search
NeoBiotechnologies
Retinol Binding Protein (RBP) Monoclonal Antibody (SPM442)
{{$productOrderCtrl.translations['antibody.pdp.commerceCard.promotion.promotions']}}
{{$productOrderCtrl.translations['antibody.pdp.commerceCard.promotion.viewpromo']}}
{{$productOrderCtrl.translations['antibody.pdp.commerceCard.promotion.promocode']}}: {{promo.promoCode}} {{promo.promoTitle}} {{promo.promoDescription}}. {{$productOrderCtrl.translations['antibody.pdp.commerceCard.promotion.learnmore']}}
产品信息
5947-MSM1X-P1ABX
种属反应
宿主/亚型
分类
类型
克隆号
抗原
偶联物
形式
浓度
规格
纯化类型
保存液
内含物
保存条件
运输条件
靶标信息
This gene encodes the carrier protein involved in the transport of retinol (vitamin A alcohol) from the liver storage site to peripheral tissue. Vitamin A is a fat-soluble vitamin necessary for growth, reproduction, differentiation of epithelial tissues, and vision. Multiple transcript variants encoding different isoforms have been found for this gene.
仅用于科研。不用于诊断过程。未经明确授权不得转售。
篇参考文献 (0)
生物信息学
蛋白别名: C CRABP-I; cellular retinol binding protein 1; Cellular retinol-binding protein; Cellular retinol-binding protein I; CRBP; CRBP-I; mCRBPI; RBP; RBP1; retinol; retinol binding; Retinol Binding Protein; retinol binding protein 1, cellular; retinol-binding protein; Retinol-binding protein 1; retinol-binding protein 1, cellular; unnamed protein product
基因别名: CRABP-I; CRBP; CRBP1; CRBPI; hCRBP1; Rbp-1; RBP1; RBPC
UniProt ID: (Human) P09455, (Mouse) Q00915, (Rat) P02696
Entrez Gene ID: (Rabbit) 100354448, (Goat) 102189996, (Human) 5947, (Mouse) 19659, (Rat) 25056